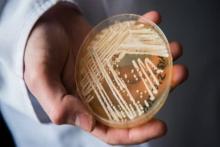
این قارچ مرگبار درحال تسخیر آمریکا است؛ آخرالزمان زامبی؟

این قارچ مرگبار درحال تسخیر آمریکا است؛ آخرالزمان زامبی؟
به گزارش سیتنا، این قارچ مرگبار بهطور نگرانکنندهای در برابر آنتیبیوکهای موجود که برای درمان عفونت استفاده میشود، مقاوم است. این پاتوژن قارچی نوظهور که کاندیدا اوریس (C.auris) نام دارد، با ایجاد عفونت میتواند سطح پوست یا سراسر بدن را درگیر کرده و از طریق تماس با سطوح آلوده یا بهصورت فرد به فرد منتقل شود.
اولین موارد ابتلا به این قارچ مرگبار در ژاپن و طی سال ۲۰۰۹ گزارش شد و ایالات متحده نیز در سال ۲۰۱۳ این مورد مبتلا را شناسایی شد. اکنون جدیدترین یافتههای محققان نشان میدهد که موارد ابتلا به این بیماری طی سالهای اخیر در ایالات متحده رو به افزایش است.
طی سال ۲۰۲۱، تقریبا ۱۴۷۱ مورد ابتلا به کاندیدا اوریس در آمریکا گزارش شده که حاکی از افزایش ۹۵ درصدی در مقایسه با سال قبل است. طی سالهای گذشته نیز موارد ابتلا به شرح زیر گزارش شده است:
سال ۲۰۲۰: ۷۵۶ ابتلا
سال ۲۰۱۹: ۴۷۶ ابتلا
سال ۲۰۱۸: ۳۳۰ ابتلا
سال ۲۰۱۷: ۱۷۳ ابتلا
براساس آخرین اطلاعات بهدست آمده از CDC، طی سال ۲۰۲۲ تاکنون حدود ۲۳۷۷ مورد ابتلا به این قارچ مرگبار شناسایی شده است. هنوز از تعداد افرادی که بهدلیل ابتلا به این عفونت جان خود را از دست دادهاند، آمار دقیقی در دست نیست. بااینحال برآورد CDC حاکی از آمار ۳۰ تا ۶۰ درصدی مرگومیر ناشی از این عفونت است.
اگرچه این عفونت برای افراد سالم بیضرر تلقی میشود، اما برای افرادی با سیستم ایمنی ضعیف، بسیار خطرناک ارزیابی شده است. بهنقل از متخصصان، غربالگری بیماران بدون علامت برای جلوگیری از سرایت آنها به افراد در معرض خطر، بهویژه در بیمارستانها و مراکز مراقبی بسیار حیاتی است.
قارچ مرگبار کاندیدا اوریس در برابر داروها مقاوم است
دادههای نظارتی حاکی از مقاومت این عفونت خطرناک در برابر داروهای ضدقارچی معروف به اکینوکاندینها هستند که بهعنوان خط اول درمانی شناخته میشوند. براساس مطالعه CDC، یکی از دلایل افزایش عفونتهای قارچی طی سالهای اخیر میتواند افزایش تعداد بستری و ازدحام در بیمارستانها به علت همهگیری کووید-۱۹ باشد.
پزشکان تاکید دارند که سختترین چالش در دور نگه داشتن این قارچ خطرناک از بیماران، بخش مراقبتهای ویژه بیمارستان است. کنترل سریع عفونت و همچنین رعایت بهداشت دستها، ایزوله کردن بیماران و حفظ نظافت محیط در کنار تشخیص زودهنگام برای محدود کردن انتقال این قارچ مرگبار، از جمله اقدامات موثر برای سرکوب این عفونت هستند.
انتهای پیام
